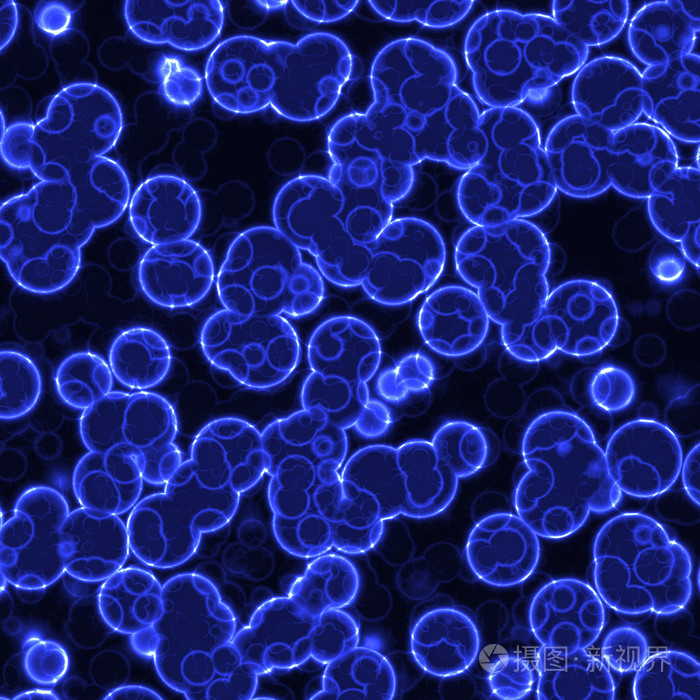

【译者之言:在我们的星球上,生命的世界丰富多彩,大的有海洋中游弋的上百吨的蓝鲸,而微小的细菌、病毒,需要借助高倍显微镜才能看到,人类对这些肉眼看不到的生物的认知,又是如何获得的呢?】

我一直发现,古希腊的历史是一座可以讲述好故事的金矿,而出于某些原因,我竟然把它们记得滚瓜烂熟。
比如,让我们说说地狄米斯托克利。他是雅典人的领袖,在波斯人即将入侵的时候,他说服这座城市,去投资建立了一支强大的舰队。公元前480年,波斯人来了,从北席卷过来,占领了雅典,并放火将其焚毁。雅典人逃到了受雅典舰队保护的岛屿上,而该舰队(加上来自希腊其他城市的舰船)正在雅典和萨拉米斯岛之间的狭长海峡,恭候着波斯舰队。
舰队名义上的领袖是斯巴达(当时希腊城市中,拥有领先军事力量的城市)的尤利比亚德。斯巴达人在陆地上的勇敢完美无缺,但到了海上却有点紧张。看到雅典已被毁灭,尤利比亚德想退守斯巴达,但狄米斯托克利却想留下继续战斗。
狄米斯托克利的想法非常固执,使得尤利比亚德对他雄辩的言辞感到恼怒,威胁性地举起了他的随从。狄米斯托克利张开双臂。
“扔呀,”他说,“但听我说。”
尤利比亚德还是决定留了下来。而狄米斯托克利为了确保他不会改变主意,又派了一名信使到波斯国王薛西斯那里,建议他将舰队部署到萨拉米斯海峡的两端,以此围困希腊舰队。
清晨,希腊舰船发现自己被围堵了,别无选择,只能一战,结果一举摧毁了波斯舰队。萨拉米斯之战是波斯战争决定性的一战。
战斗结束之后,希腊舰船的舰长们聚集在一起,投票选举这场伟大胜利的功臣。每个舰长都投票将自己放在第一名,而将狄米斯托克利放在了第二名。
有故事说,即使是处于其人生巅峰期的时候,狄米斯托克利还是被来自希腊某个偏远小镇的希腊人嘲笑过。这个人说,“如果你恰巧出生在我的小镇上,你是不会这样出名的。”而狄米斯托克利回答道,“如果你恰巧出生在雅典,你也不会出名的。”
而我最喜爱的有关狄米斯托克利的故事是,他指着襁褓中的儿子说道,“希腊有统治者了,”
“那个小孩吗!”其他某个人惊讶地说道。
“当然是,”狄米斯托克利说,“因为雅典统治希腊,我又统治雅典,而我的妻子统治我,这个小孩又统治我的妻子。”
好吧!让我们看看地球的统治者是谁。
· · ·
回到十七世纪后期,有一位名叫安东·范·列文虎克(Anton van Leewenhoek (1632-1723年)的荷兰人,他有磨制小透镜的爱好。他的一些优秀作品比大头针的针头大不了多少,但通过它们,他能将微小的东西放大200倍。在那个时代,不会再有其他人看东西,能比他看得更清楚了。他在五十年的时间内磨制了总共419片透镜,一直工作到他漫长生命的尽头。

他在1673年首先发现了单细胞生物,这些生物太过微小,不借助显微镜是看不到的, 但毫无疑问,它们仍然像巨大的鲸鱼一样活着。他还看到了毛细血管和红细胞,以及酵母细胞和精子。
1683年,在他借助最好的镜头观察微小的东西,并为它们绘图的时候,他有了最大的发现。他不知道发现的是什么,而其他人也是在下一个世纪才看到它们的。但是,看到他绘制的图,我们知道,范·列文虎克是第一个看到细菌的人。

当然,范·列文虎克并没有将它们叫做细菌。他将他所看到的所有微小生物都称为“animacules”(拉丁语,意思是“小动物”)。今天,我们将它们统称为“microorganisms(微生物)”(希腊语,意思是“小动物”)。
而第一个试图研究细菌的人是丹麦生物学家奥托·弗里德里希·穆勒 (Otto Friedrich Muller)(1730-1784年)。1786年,在他死后出版的一本书中,记录了他的观察结果。
穆勒也是第一个试图对微生物进行一般分类的人;就是说,将微生物分类成时尚的种和属,这种分类是由瑞士自然学家卡罗勒斯·林奈(Carolus Linnaeus) (1730-1784年)在半个世纪前就开始推广的。然而,林奈研究的是肉眼能看到的动物和植物,可以依据清楚看到部分详细的差异性和类似性,对它们进行分类。
而另一方面,微生物却非常微小,在它们之中看不清多少细节。除了按照它们的总体形状对它们进行判断以外, 其它什么也做不了。这就如同通过普通植物和动物投下的影子对它们进行分类一样。但是穆勒还是注意到,一些细菌像棍子,一些像开塞钻。他将前者称为“bacilli”,或者单数“bacillus”(拉丁语,意思是“小棍子”);而将后者称为“spirilla”,或者单数“spirillum”(拉丁语,意思为“小螺旋”)。

单词“spirilla”保留了其特指的意思,但“bacilli”有时会被用作细菌(bacteria)的同义词。
在穆勒的时代,任何人看细菌,都不太可能比穆勒看得更清楚了。显微镜中使用的透镜在光线波长发生变化时,会将光线以不同的程度折射进显微镜。你可以聚焦某一种波长的光线,而其它波长的光线则无法同时聚焦,这样就会看到观察对象周围模糊的色环。
1830年,英国透镜制造商约瑟夫·杰克逊·利斯特(Joseph Jackson Lister)(1786-1869年),成功地采用两种不同的玻璃,组合出显微镜透镜。每种透镜折射光线的波长有所不同,如果将它们合理组合,一种透镜的颜色效应就正好能被另外一种透镜的颜色效应所抵消。它也就成了一种“achromatic(希腊语,意思是“没有颜色”) 透镜”)。
使用“无颜色透镜”,聚焦可以变得非常清晰,没有了模糊的色环。只有这样,对细菌等微小东西的研究,才能够以有意义的方式展开。
十九世纪六十年代,法国化学家路易·巴斯德(Louis Pasteur)(1822-1895年)开始坚持认为,传染性疾病是人与人之间通过特定微生物传染的结果。这是有史以来最伟大的单项医学发现,它也将人们的注意力成功地集中在了微生物身上。
受到巴斯德研究工作的鼓舞,德国植物学家费迪南德·朱利叶斯·科恩 (Ferdinand Julius Cohn)(1828-1898年)成为世界上第一个,将其毕生的研究工作专注在细菌上的科学家。1872年,他发表了三篇有关细菌的论文,由此创立了细菌学科学。在细菌分类方面,他比穆勒有了很大的进展。他是第一个描述细菌孢子及其耐沸温度的科学家。
科恩延续了穆勒的“bacilli”和“spirilla”细菌分类,但走得更远。他注意到,一些棍状的细菌比另一些长,他保留了较长棍状细菌的“bacilli”名称,而对于较短的细菌,他第一次使用了“bacteria”,或者单数“bacterium”(同样为拉丁语,意思是“短棍子”)这个名称。
出于某些原因,“bacteria”开始成为最常用于这些微生物的术语,尽管人们也用过一些其它术语。于是,德国病理学家克里斯蒂安A·T·比尔罗斯(Christian Billroth)(1829-1894年)将具有小球形状的细菌称为“cocci(球菌)”或单数“coccus”(希腊语,“浆果”),还有一些种类则称为“streptococcus(链球菌)”,“staphylococcus(葡萄球菌)”和“pneumococcus(肺炎球菌)”。
法国生物学家查尔斯·塞迪悦(Charles Sedillot)还引入了术语“microbe”(希腊语,意思是“小生命”),用于引起疾病、腐烂或发酵的所有微生物。有时,“microbe”也是通常用于细菌的另一个术语。
19世纪初,还有一个最不适合于细菌的的术语,但公众却经常使用。它就是“germ”(拉丁语中“胚芽”的意思),它可以用来表示,生命起源的任何小物体。
于是,种子中含有实际生命物质的部分,可以被认为是细菌,以致于我们会说出“小麦细菌”这样的东西。同样,生命来自精子和卵子,于是它们被称为“细菌细胞”。在发育的胚胎中,最终发育成器官的原始细胞群,则被称为“细菌层”。
事实上,巴斯德对传染病的看法,通常被称为“疾病的细菌理论”,这实际上是不正确的,因为细菌绝不是唯一的致病生物。疾病也可以由病毒、霉菌、原生动物、寄生虫等引起。
· · ·
区分细菌与其他细胞,最明显的特性是看它们的大小。非细菌的单细胞生物可能大到几乎能肉眼看到。它们必须这么大,因为它们需要将大量功能,打包进它们的单个细胞中。例如,一个变形虫(amoeba)的直径可达约为200微米(1/125英寸)。

组成多细胞生物的细胞比这个要小。它们不必满载独立生存所需的材料。它们可以与其它细胞共享劳动成果。例如,人类的肝细胞直径约为12微米。一个变形虫可以容纳大约2400个人类的肝细胞。
而一个典型的细菌,直径可能只有2微米。细菌应该是地球上自由生活的最小(或者可能是最小)生物。我们所知道的最小细菌,直径大约只有0.02微米。一个变形虫细胞中可以容纳大约1亿个这些最小的细菌。
(还有一些被称为病毒的生物,它们比细菌还要小,但它们都不能自由生活。它们只能在活细胞内生长和繁殖。)
细菌在生命的层次结构中应该属于哪一层呢?当我年轻的时候,我知道所有的生命被分成两个王国,植物王国和动物王国。我发现,将细菌放在植物王国里,有点不合适。要不然,让植物王国和动物王国只包括多细胞生物,而让所有的单细胞生命组成了第三个王国,称之为“Protista”(希腊语,意思是“第一个”)。
要理解这一观点,我们必须追溯到1831年。当时,英国植物学家罗伯特·布朗(Robert Brown)(1773-1858年)第一个注意到,普通细胞内部有微小的结构。他将它们称为“nuclei(核)”,或单数“nucleus”(拉丁语,意思是“小坚果”),因为它们是在细胞内被发现的,就像硬壳内的坚果。
最终证明,细胞核包含了控制细胞繁殖的遗传物质。遗传物质在细胞分裂过程中自我复制,并几近精确地复制母细胞,传递到子细胞;从更大的意义上来说,就是从母生物体复制到子生物体。
所有多细胞生物中的每个完整细胞,都包含一个细胞核,无论这些生物是植物还是动物。(可以肯定的是,也存在不完整的细胞,如红细胞,它们不包含细胞核。但它们寿命很短,既不生长,也不分裂)。
因此,多细胞的动物和植物,都可以被归类为由有核细胞组成,或者由“eukaryotes(真核细胞)”(希腊语,意思为“真正的核”)组成。此外,单细胞动物细胞,如变形虫和单细胞植物细胞(如“algae”藻类,或单数“alga”(拉丁语中的“海藻”)),都是真核细胞。
换句话说,植物和动物(包括所有的多细胞形式,以及较大的单细胞形式)可以被认为形成了一个“真核生物”的“超级王国”。
另一方面,细菌细胞并不包含细胞核。但这并不意味着,它们不包含生长和繁殖所必需的遗传物质。这些遗传物质只是没有被隔离在细胞核中,而是分布在整个细菌细胞中。或者你也可以说,细菌细胞本质上就是一种自由生活的细胞核。这也是它为什们这么小的原因。(不过,细菌细胞还是包含了真核细胞中细胞核外的结构。)
细菌细胞,以及事实上不包含明确分隔的核,但在细胞中分布有遗传物质的任何细胞,都是“prokaryotes(原核生物)”(希腊语,意思是“核之前”),可以认为它们包括在“原核生物”的超级王国中。这样,我们就可以把生物分成了两大部分:细菌和其他所有生物。
“原核生物”一词意味着,细菌比真核生物更原始,因此,它们可能在真核生物存在和进化之前,就已经存在和进化了。
如果回到化石记录中,我们会发现,我们正在处理的是多细胞生物的遗迹,它们与我们自身有类似的复杂性,而且它们中许多体型也相当大。从它们与今天生活的生物的相似处来看,很明显,所有这些化石都是真核生物。
我们发现的最古老的化石大约有6亿年的历史,但它们并不能代表最古老的生命形式。因为,首先,即使是最古老的化石的结构也是相当复杂的,一定已经有了很长的进化历史。另外,地球有46亿年的历史,所以普通的化石遗迹,只占据了地球历史的最后八分之一多一点,在这之前应该还有足够的时间进行早期的进化。
事实上,我们通常研究的化石,主要都是那些设法进化出坚硬结构——外壳、骨骼、牙齿(它们更容易变成化石)的多细胞生物。在它们之前,一定还有不带坚硬结构的多细胞生物,而其中最早的,可能已经有8亿年的历史了。
我们可以往回走得更远一些。美国古生物学家埃尔索·斯特伦伯格·巴格霍恩(Elso Sterrenberg Barghoorn)(1915-1984年)从1954年开始,在安大略省南部,研究了非常古老的岩石。他将这些岩石制成薄片,并在显微镜下进行了研究。在这些岩石中,他发现了与原生动物尺寸大致相同的圆形结构。此外,在这些残骸中还有更小结构的迹象,它们类似于细胞内的结构。
很明显,这些都是单细胞生物的化石,其中最古老的一个似乎已经有14亿年的历史了,其年龄几乎是最古老多细胞生物的两倍。但即便如此,真核生物的历史似乎仍然被压缩到地球历史的最后三分之一多一点。更重要的是,真核生物足够复杂,即使是单细胞形式,也需要很长的进化历史。
当然,巴格霍恩和他的同事们在岩石中还发现了特别小的结构,它们太古老了,没有包含真核生物。现在看来,原核生物比真核生物早了很长一段时间。迄今为止,在岩石中发现的最古老的原核生物残骸,可能已有35亿年的历史了。
这意味着,在地球年龄最多只有10亿年的时候,原核生物就已经存在了。而在此后的20多亿年里,它们一直是地球上唯一的生命形式,是地球真正的统治者。
· · ·
真核生物一旦出现,在我们看来,它们就接管了地球的统治地位,首先是单细胞植物和动物,然后是各种各样的多细胞动植物和动物。海洋的主要生物(鱼类)和陆地的主要生物(两栖动物、爬行动物,然后是哺乳动物,尤其是人类)都是真核生物。
不过,这要看你如何定义“统治地位”了?地球上植物生命的数量是动物生命的十倍,动物只能作为寄生物生活在植物世界中。如果所有的植物都消失了,所有的动物生命很快就会跟随它们走向毁灭。而如果所有的动物都消失了,地球上大部分植物仍会活着。
对于一个真正客观的外星观察者来说,地球似乎是一个植物的世界,一些高级的树木是“统治者”,到处有自由跑动的、令人讨厌的和不无关紧要的寄生物。(毕竟,人体是由数以万亿计的人体细胞,以及皮肤上和肠道中感染的、令人讨厌的和无关紧要的寄生虫组成的。这些寄生虫不是我们的统治者,因为它们依靠我们生活)
我们也可以用另一种方式来看这个问题,真核细胞是如何发展出来的?有些人认为它们是通过各种类型的原核细胞的合作和最终合并而产生的。
因此,具有完善遗传机制的原核细胞,会与其他带有完善的游离氧处理系统的原核细胞相结合。结合的时候,原始的真核细胞发育出一个十分适合遗传功能的细胞核,在它外面,还有一个十分适合处理氧的线粒体。细胞的其他部分,也来自于各种适当的专业化原核细胞。
简而言之,真核细胞可能只是原核细胞的组合,就像多细胞动植物都是真核细胞的组合一样。这一观点得到了美国生物学家林恩·马古利斯(Lynn Margulis)(生于1938年)的强烈支持。
因此,我们可以把地球上所有的生命分为三类:(1)原核细胞,如细菌;(2)原核细胞的组合,如变形虫;以及(3)原核细胞组合的组合,如人类。
作一个类比,我们可以这样看,美国的一个州是人的组合;而美国联邦政府又是州的组合(人组合的组合)。
一个优秀、高效、仁爱的政府,会让人民过上一种,比完全孤立、完全依靠自己资源更好的生活。而美国人的观点同样是,人民是最基本的。毕竟,如果没有政府,无论多么野蛮和糟糕,人民都会生存,但如果没有了人民,政府就不可能存在。
所以,我忍不住还是会说,原核生物仍然统治着地球。
让我们从另一个角度来理解这个问题。虽然真核生物在14亿年前就存在了,而且8亿年前可能还出现了第一个多细胞生物,但原核生物仍然存在并仍然在蓬勃发展。
它们存在的数量非常巨大,且繁殖的速度非常的快,因此它们的进化速度,比单细胞或多细胞真核生物也要快得多。结果是,原核生物已经进化出,真核生物无法对付的环境生态位。它们可以生活在能够杀死真核生物的温度和盐浓度下。它们可以生活在无法支持其他生命形式的无机化合物上。作为孢子,在恶劣的条件下,它们可以比任何其他形式的生命,生存更长的时间。当我们开发出化学药品来杀死它们时, 它们会逐渐形成耐药性,如果我们要控制住它们,就必须不停地找到新的杀菌药。它们是不可战胜的,在出现一些毁灭生命的宇宙或人类大灾难时,即使所有其他的生命都消失了,原核生物仍可能很好地生存下来。
那么,如果不带偏见或自我感觉的话,你认为谁是地球真正的统治者呢?
· · ·
目前仍然存在细菌分类的问题。第一批细菌学家,比如:马勒和科恩,他们试图只凭外表把它们分开,最后我们只得到了一组名字,而无法知道不同的物种是如何相关的。
最终,随着生化技术的进步,当细菌学家们学会了研究细胞成分的化学性质、它们所拥有的基因以及它们带来的化学反应类型的时候,探索原核生物进化和确定它们的关系的机会也就大大提升了。
最近,科学家设计了一个判断细菌关系的系统,它包括“核糖体”,这是所有细胞中参与蛋白质合成的物质,真核细胞和原核细胞中都有。由于每个细胞独特的特性是由其中的化学反应赋予它的,而且由于这些化学反应取决于所形成的蛋白质的性质,因此核糖体似乎只能随着时间缓慢发生变化。(它们对其可能形成的蛋白质类型没有太多的自由空间。)因此,通过两种生物核糖体之间的差异,就可能很好地衡量它们之间进化的差距。
在核糖体的基础上,我们发现细菌分为两个不同的群。我们经常遇到一些常见的细菌,它们的化学反应与一般细胞普遍很相似。它们是“eubacteria(真细菌)”(希腊语,意思是“真正的细菌”)。
也有些细菌,它们的核糖体中似乎有很大的不同,因此,毫不奇怪,它们在化学反应和生存方式上也很不寻常。这些是“archaebacteria(原始细菌)”(希腊语,意思是“老的细菌”)。
在核糖体化学组成方面,原始细菌和真细菌与来自真核生物的一样相互不同。这意味着,我们现在可以把所有生活在地球上的已知生物,分为三个超级王国:真核生物、真细菌和原始细菌。
据推测,原始细菌是我们所知道的最古老、最原始的自由生活的生物,它们包括三个已知的亚群。有些细菌不能使用氧气,带有的化学物质最终会产生甲烷,而不是二氧化碳。它们是“methanogens(产甲烷菌)”(希腊语,意思为“甲烷制造者”)。还有的细菌能在高温酸性的海水中茁壮成长,它们是“thermoacidophiles(嗜热嗜酸菌)”(希腊语,意思为“热酸爱好者”)。最后,还有一些细菌喜欢非常咸的水,它们是“halo bacteria(嗜盐菌)”(希腊语,意思为“盐细菌”)。
这三种已知的原始细菌可能来自一个共同的祖先。而我们仍然还不知道这个共同的祖先,要么是因为它已经不存在了,要么是因为我们还没有发现它。我所看到的,用于这种最原始细胞的一个名字是“progenotes(原生命)”(希腊语,意思是“出生之前”)。
从这些原始细菌中,可能产生了真细菌和真核生物。我们不知道它们是否分别来自于不同种类的原始细菌群。有一个说法是,第一个真细菌是从嗜热嗜酸菌进化而来的,而第一个真核细胞来自产甲烷菌,但我对此持怀疑态度。
我认为真细菌最初起源于一群原始细菌,然后是真细菌的组合发展为真核细胞。我没有证据,但我这个人就是这样的,喜欢胡乱猜测。
真细菌分成许多亚群,其中一个含有叶绿素的亚群特别有趣。由于含有单细胞叶绿素的生物中,最有名的是藻类,单从颜色上看,这些真细菌很长时间里一直被称为“蓝绿藻”。
然而,它们并不是藻类。藻类是真核生物,而这种所谓的“蓝绿藻”却是原核生物。它们属于不同的超级王国。
因此,“蓝绿藻”最初又被称为“蓝绿色”,这是一种怯懦的妥协,然后才被称为“cyanobacteria(蓝细菌)”(希腊语,意思为“蓝色细菌”)。
蓝细菌可能与其他真细菌结合,形成了现在的“叶绿体”,即植物细胞中含有叶绿素的结构。
蓝细菌在过去20亿年里一直在产生氧气,它们可能是世界上唯一的光合作用系统。因此,我们都得感谢蓝细菌,是它开始在地球建立起了含氧大气层,供大家呼吸。
(作者:艾萨克.阿西莫夫(Isaac Asimov),译者:劲松)
来源: The True Rulers


 科普中国公众号
科普中国公众号
 科普中国微博
科普中国微博

 帮助
帮助
 劲松科普
劲松科普 